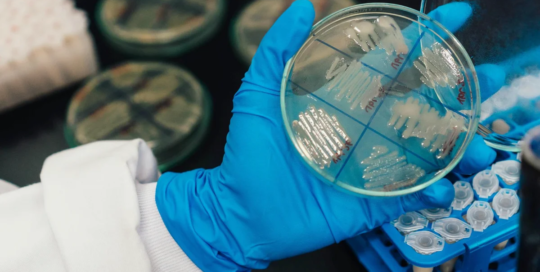

그들은 동물과 야생 동물의 기원, 행동, 질병, 유전학, 그리고 생활 과정을 연구합니다. 야생 동물 연구 및 관리를 전문으로 합니다. 또한, 생물학적 데이터를 수집하고 분석하여 육지 및 수생 서식지의 현재 및 잠재적 이용이 환경에 미치는 영향을 파악합니다.
미생물학자들
2025-10-22T08:37:25-06:00이들은 박테리아, 조류, 균류와 같은 미세 유기체의 성장, 구조, 발달 및 기타 특성을 연구합니다. 유기체와 질병의 관계 또는 항생제가 미생물에 미치는 영향을 연구하는 의학 미생물학자도 포함됩니다.
생화학자와 생물물리학자
2025-10-22T08:37:23-06:00그들은 살아있는 세포와 유기체의 화학적 조성이나 물리적 원리, 전기적 및 기계적 에너지, 그리고 관련 현상을 연구합니다. 또한 대사, 생식, 성장, 유전에 관여하는 조합과 반응에 대한 연구를 수행합니다. 또한 음식, 약물, 혈청, 호르몬 및 기타 물질이 생명체에 미치는 영향을 규명합니다.
토양 및 식물 과학자
2025-10-22T08:37:20-06:00그들은 작물 및 농작물, 수목, 관목, 묘목의 육종, 생리학, 생산, 수확량 및 관리, 토양 내 생장, 그리고 해충 방제에 관한 연구를 수행합니다. 토양의 화학적, 물리적, 생물학적, 그리고 광물학적 구성을 연구하며, 토양 및 작물 생산성에 대한 대안적 관행을 연구합니다.
나노기술 공학 기술자
2025-10-22T08:37:08-06:00그들은 나노스케일 설계를 위한 생산 공정을 구현하여 독특한 분자 또는 거대분자 구성을 가진 재료, 장치 또는 시스템을 생산하거나 수정합니다. 또한, 나노스케일 물체를 조작하기 위해 첨단 현미경 장비를 조작하며, 나노공학 직원의 감독 하에 업무를 수행합니다.
검증 엔지니어
2025-10-22T08:35:16-06:00그들은 내부 및 외부 순도, 안전성, 품질 요구 사항을 충족하는 제품을 생산하기 위해 장비나 프로세스에 대한 프로토콜을 설계하거나 계획합니다.
생화학 엔지니어
2025-10-22T08:35:14-06:00그들은 생물학, 화학 또는 공학 지식을 활용하여 사용 가능하고 실제적인 제품을 개발합니다. 또한, 인간, 식물, 동물, 미생물 또는 생물학적 물질과 상호 작용하는 재료, 시스템 또는 프로세스와 관련된 문제를 해결합니다.
기계 엔지니어
2025-10-22T08:34:54-06:00이들은 도구, 엔진, 기계 및 기타 기계 작동 장비를 계획하고 설계하는 엔지니어링 업무를 수행합니다. 중앙 난방, 가스, 수도, 증기 시스템 등의 장비 설치, 운영, 유지보수 및 수리를 감독합니다.